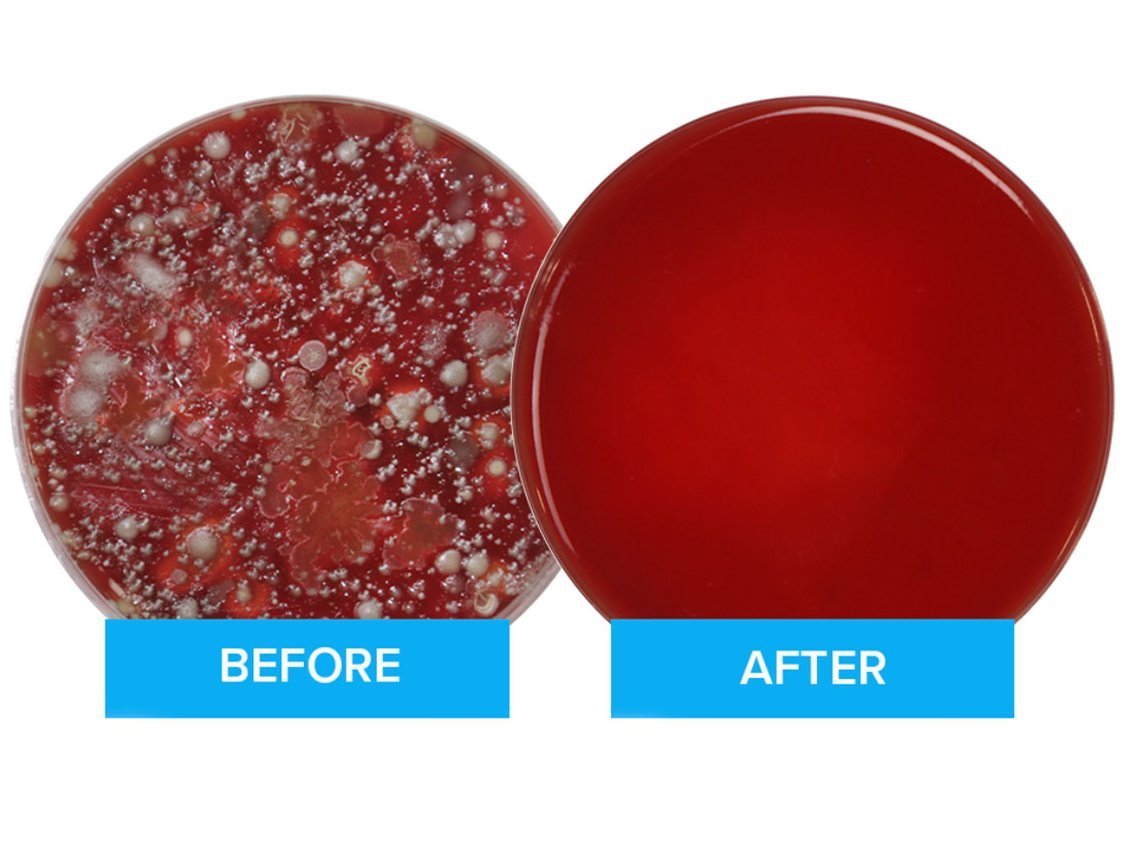
便器の18倍の菌

あなたのスマホには便器の
18倍の菌が付着しているかも?
PhoneSoapを使えば、10分で99.9%除菌することが可能です。
PhoneSoap はアメリカ・ユタ州で開発された、あなたのスマホを 99.9% 除菌できる次世代のプロダクトです。USBコネクタが付いているので、除菌中にスマホを充電することもできます。スマホ以外にも、カギ、お金、イヤフォンなど、様々なものを除菌できます。
↓↓Amazon・楽天・公式サイトで好評発売中↓↓
PhoneSoap の魅力を動画でチェック
除菌しながら充電も

PhoneSoap を使えば、スマートフォンを除菌しながら充電もできます。おやすみ前にスマートフォンを PhoneSoap に入れてしまえば、翌朝にはキレイなスマホを使うことができます。
寝室はもちろん、キッチン、オフィス、玄関など色々な場所で活躍します。
あなたのスマホには
便器の18倍の菌が付いているかも?
米国ダコタ大学での調査によると、スマートフォンには便器の18倍の菌が付いていることが分かりました。
- トイレでついスマホを使ってメールチェックしてしまう方
- 満員電車の吊り革を触ったあとでスマホでニュースを見てしまう方
- つい食材を触ったあとでスマホでレシピサイトを見てしまう方
手に付いた汚れは全てあなたのスマホについています。
アルコールや化学物質を
使わない安心除菌

PhoneSoap(フォンソープ)は、UV-Cという特殊な紫外線を使ってスマホ表面を除菌します。
PhoneSoap の本体内部には上下に UV-C バルブがあるため、360度あらゆる方向から紫外線を照射することができます。
アルコールや化学物質を使わないため、小さなお子様や高齢者の方がいるご家庭でも安心です。
PhoneSoap 4つの特徴
いつでも99.9%除菌
UV-Cという特殊な紫外線を使って、簡単に除菌ができます。熱、液体、化学薬品を使わないため、安心な除菌方法です。
除菌しながら充電できる
本体裏側に USB ポートと USB-C ポートがあります。ここにスマホ充電用のケーブルを挿すと、除菌しながらスマホを充電することができます。
スマホ以外も除菌できる
フォンソープはスマホ以外にも使えます。スマートウォッチ、イヤフォン、お金、クレジットカード、カギなど、サイズが合うものなら何でも除菌することができます。
ほぼ全てのスマホに使える
フォンソープは、現在流通しているほぼ全てのスマートフォンに使用することができます。iPhone XS Max のような大型のスマホでも使用可能です。
スマートフォン収納部サイズ:173 × 95 × 20 mm
PhoneSoap の使い方
↓ ご購入はこちら ↓
製品仕様
| 外寸サイズ | 20.6 × 12.7 × 4.5 cm |
|---|---|
| 内寸サイズ | 17.3 × 9.5 × 1.98 cm |
| 電源 | AC アダプタ(付属) |
| コネクタ仕様 | USB タイプA / タイプC (タイプCは給電・放電どちらも可能) |
|---|---|
| UVバルブ | 10.5 cm、上下1本ずつの合計2本 |
| UV-C 周波数 | 254 nm |
日本仕様版の型番と JAN(GS1)コード
| ブラック PS3J-B | 4589840511489 |
|---|---|
| ホワイト PS3J-W | 4589840511618 |
| ゴールド PS3J-G | 4589840511632 |
| シルバー PS3J-S | 4589840511625 |
| ペリウィンクル PS3J-P | 4589840511656 |
|---|---|
| オーキッド PS3J-O | 4589840511649 |
| アクア PS3J-A | 4589840511663 |
米国仕様版の型番と EAN(UPC)コード
| ブラック Black 3.0 | 0635909961567 |
|---|---|
| ホワイト White 3.0 | 0635909961550 |
| ゴールド Gold 3.0 | 0670875603165 |
| シルバー Silver 3.0 | 0670875603158 |
| ペリウィンクル Periwinkle 3.0 | 0670875603141 |
|---|---|
| オーキッド Orchid 3.0 | 0635909961611 |
| アクア Aqua 3.0 | 0635909961604 |
お問い合わせ
PhoneSoap についてのお問い合わせ、取材依頼などはこちらのフォームからお願いいたします。
※こちらのフォームから営業メッセージを送るのは禁止です。ルールを守ってご利用ください。






